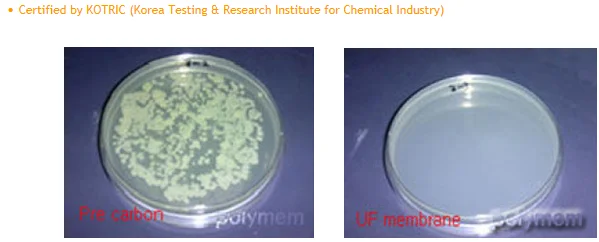
20190817_113623.png

UF Membrane Filter

Characteristics of Ultrafiltration Membrane
UF membrane with pore sizes in the range of 0.1 to 0.001 micron typically remove high molecular-weight substances, colloidal materials, and organic and inorganic polymeric molecules, bacteria except minerals. Low applied pressures are sufficient to achieve high flux rates from an ultrafiltration membrane.
Flux of a membrane is defined as the amount of permeate produced per unit. our UF filter shows
excellent water permeability. The flux varies between 50 and 200 GFD at an operating pressure of about 50psig in contrast, Reverse osmosis membranes only produce between 10 to 30GFD at 200 to 400psig.
Quality properties of resistance to acid and alkali, high flow-rate, non-toxicity, no-taste and stable performance.
Advantages:
1.Highthroughputofproduct
2.Lowprocesscost
3.Easeofscale-up
Application:
1.Fractionationofproteinsandnucleicacids
2.Concentration of macromolecules
3.Desalting,i.e.removal or salts and other low molecular weight compounds from solution of macromolecules
4.Removal of cells and cell debris from fermentation broth
5.Virusremoval fromtherapeuticproducts

Ultrafiltration Membranes
Basically UF membrane modules come in plate-and frame, spiral-would, and tubular
configurations.
All configurations have been used successfully in different process applications. each configuration is specially suited for some specific applications and there are many applications where more than one configuration is appropriate. For high purity water, spiral-wound and capillary configurations are generally used. The configuration selected depends on the type and concentration of colloidal material or emulsion.
Factors Affecting the Performance of Ultrafiltration.
Flow Across the Membrane Surface.
The permeate rate increases with the flow velocity of the liquid across the membrane surface. Higher flow also means higher energy consumption and larger pumps. Increasing the flow velocity also reduces the fouling of the membrane surface. Generally, an optimum flow velocity is arrived at by a compromise between the pump horsepower and increase in permeate rate.
Operating Pressure.
Permeate rate is directly proportional to the applied pressure across the membrane surface. However, due to increased fouling and compaction, the operating pressures rarely exceed 100psig and are generally around 50psig. In some of the capillary-type ultrafiltration membrane modules the operating pressures are even lower due to the physical strength limitation imposed by the membrane module.
Flow Across the Membrane Surface.
Permeate rates increase with increasing temperature. However, temperature generally is not a controlled variable. It is important to know the effect of temperature on membrane flux in order to distinguish between a drop in permeate due to a drop in temperature and the effect of other parameters.
Membrane Materials
A variety of materials have been used for commercial ultrafiltration membranes, but polysulfone and cellulose acetate are the most common. For high purity water applications the membrane module materials must be compatible with chemicals such as hydrogen peroxide used in sanitizing the membranes on a periodic basis.
Pressure Resistance
1. Applied pressure: 0.5~4 kgf/cm
2. Resident time at each pressure: 5 minutes
3. Maximum operating pressure: 4 kgf/cm?
Particle Size Cut Off Character
1. Standard particles: Polystyrene latex bead(Sigma, Mean dia.: 0.03, 0.05 ¼m)
2. Pressure: 1 kgf/cm?BR>3.Analysis: UV Spectrometer(»=320 nm)
4. Influent: 100 ppm aqueous suspension
5. Effluent: 7.5 ppmfor 0.03 ¼m(92.5 % rejected) , 1.5 ppmfor 0.05 ¼m(98.5 % rejected)

With priority to our clients’ good health in our mind, we, WACO Corp.(old hyundai wacortec co., ltd.) as the world leader and specialist in Water Purifiers, Dispensers, Air Purifiers as well other well-being products have enjoyed a great reputation of the various selections, highest quality, and advanced technology as well our commitment since established.
With the good design of our products and their durability at a reasonable price, We are dedicated to giving you a better life and benefits.
Our motto-Accuracy, Technical Innovation, Superiority in quality and Perfect Service-represents that we’ll do our best to give pure, fresh, clean water and air and also to keep our customers healthy with our well-being products.
We appreciate your continuing support and interest and in return we do our best for you.
Thank you.
New products from manufacturers at wholesale prices